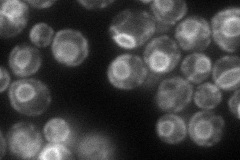
YNR026C
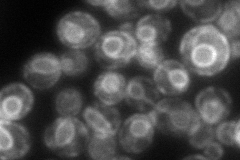
YNR026C
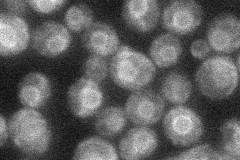
YNR026C
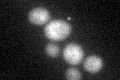
YNR026C

View description
Guanine nucleotide exchange factor (GEF), activates Sar1p by catalyzing the exchange of GDP for GTP; required for the initiation of COPII vesicle formation in ER to Golgi transport; glycosylated integral membrane protein of the ER
Localization:
Intensity:
Fold change:
Significance:
-
C’ GFP library in SD

below threshold13.33 -
N' NOP1pr-GFP in SD
ER88.4956 -
N' TEF2pr-mCherry in SD
ER106.211 -
N' NATIVEpr-GFP in SD
ER36.7689 -
N' TEF2pr-VC and Cyto-VN in SD

ER34.3034 -
C’ GFP library in SD+DTT
cytosol14.511.08No -
C’ GFP library in SD+H2O2

cytosol13.080.98No -
C’ GFP library in Starvation Media

cytosol17.321.29No -
C’ GFP library on the background of Pup2-DaMP

below threshold -
C’ GFP library on the background of CCT mutant

below threshold14.28931.07091No
